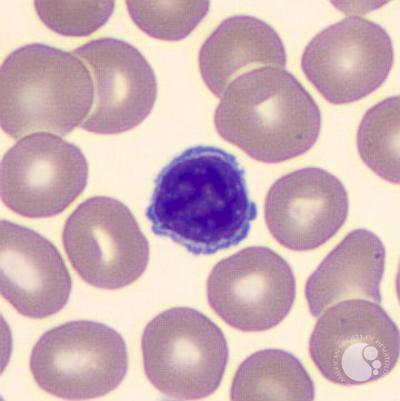

What are the functions of blood films?
Detecting blood cell abnormalities or if patients have disease detectable in blood cells e.g. malaria
What information do blood films give and when are they requested?
Information on RBCS, WBS and platelets
When a patient has returned from a country where a disease is endemic
Usually performed with full blood count
What is a white cell differential and what is it used for?
Shows the proportions of WBCs in blood
Helps determine type of infection (bacterial, viral, parasitic)
How would you do a blood film?
- Take two microscope slides and clean them with ethanol on tissue
- Place one drop of blood on one end of one of the slides - creates monolayer to examine microscopically
- Hold the other slide at a 45 degree angle and slide it on the other slide until it reaches the blood
- Draw back the slide along the other slide
- Slide is then dried
What effect is seen on the slide when doing a blood film?
Feathered effect
Which type of WBC is this?

Eosinophil - bilobed nucleus
Which type of WBC is this?
Lymphocyte: large nucleus, not grainy
Which type of WBC is this?

Neutrophil - multi lobed nucleus
Which type of WBC is this?

Basophil - grainy, single nucleus
Which type of WBC is this?

Monocyte - kidney bean nucleus
What is the difference between gram positive and gram negative cell walls?
Gram positive have a thicker peptidoglycan wall
What is the order of stains in gram staining and what colour are they a each stage?
Crystal violet: put on both samples then washed, both purple
Grams iodine: traps dye in cell, incubated then washed, both purple
Ethanol: decolours gram negative bacteria, rinsed with water, neg = colourless, positive purple
Safranin: pink counterstain, gram pos purple, neg pink
What should always be performed when doing gram staining and why?
Controls: to ensure staining process has been carried out correctly
Why is gram staining done?
To identify which type/species of bacteria is present
Which type of parasitic egg is this?

Trichuriasis
Which type of parasitic egg is this?

Schistosomasis
What type of parasitic egg is this?

Ascaris
Why is oil immersion used?
Used with light microscope to see bacteria to give x1000 magnification , prevents
How can the immune system be improved to reduce disease caused by an infection?
By getting the infection/vaccinayion
Which virus has been made extinct through vaccination?
Smallpox
Give examples of things there are vaccinations for
Flu, cholera, polio, chickenpox, hep B
Examples of some physical barriers to infection?
Epithelial cells joined by tight junctions
Movement of mucus by cilia
Normal flora
Low ph in gut
Where are WBCs made?
the bone marrow - mostly pelvic area in adults, leg bones in children
Which cells are produced from a common myeloid progenitor?
Erythrocytes, megakaryocyte, mast cells, myeloblasts, basophils, neutrophils, eosinophils and monocytes



